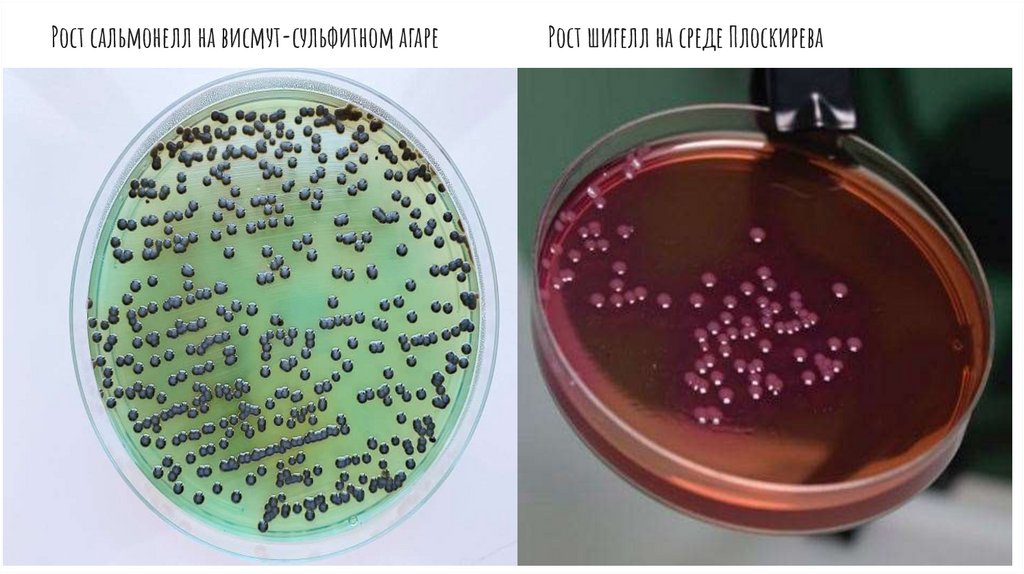

Similar presentations:
Питательные среды
1.
Питательные среды2.
Классификация питательных сред по консистенции:Жидкие
Полужидкие
Плотные
3.
Классификация по назначению:Общего назначения
Селективные
Дифференциально-диагностические
4.
5.
Рост сальмонелл на висмут-сульфитном агареРост шигелл на среде Плоскирева
6.
7.
Приготовление питательных сред: 1) Подготовка посуды2) Контроль сырья и ингредиентов
8.
3) Варка среды и установление оптимальной величины pHсреды
9.
4) Осветление раствора5) Розлив среды

chemistry
chemistry








